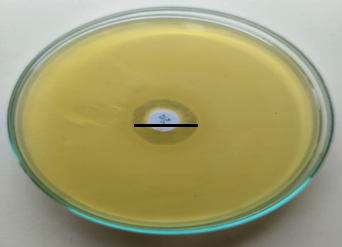
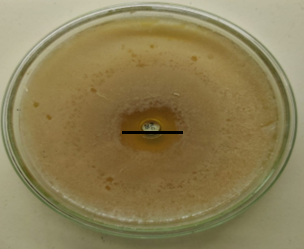

Int J App Pharm, Vol 17, Issue 6, 2025, 551-559Original Article
FORMULATION AND OPTIMIZATION OF A GALLIC ACID-LOADED NAIL SERUM USING FACTORIAL DESIGN FOR ENHANCED NAIL DELIVERY
JANE GLENISHA LOBO, JOEL SYLVESTER SALDANHA, DIYA POLALI, JENITTA MARIA CARMEL, ASHWINI MADHAVA*
Nitte (Deemed to be University), NGSM Institute of Pharmaceutical Sciences (NGSMIPS), Department of Pharmaceutics, Mangalore, India
*Corresponding author: Ashwini Madhava; *Email: ashwini.m@nitte.edu.in
Received: 20 Jun 2025, Revised and Accepted: 23 Aug 2025
ABSTRACT
Objective: Onychomycosis is a persistent fungal infection of the nails, and conventional treatments, including oral antifungals, are often associated with systemic side effects, such as hepatotoxicity, and exhibit high recurrence rates. In response to these challenges, the present project aimed to develop a novel gallic acid-loaded nail serum, a unique approach that leverages the antifungal, antioxidant, and anti-inflammatory properties of gallic acid to formulate a safer and more efficacious topical treatment than conventional therapy.
Methods: The formulations were developed using a 2³ factorial design approach to optimize the concentrations of acetone, ethyl acetate, and glycerol for desired viscosity and spreadability. The serum was evaluated for its physical characteristics, viscosity, spreadability, in vitro drug permeation, antifungal activity, and in vitro cytocompatibility using the MTT assay on L929 fibroblast cells, as well as its ex vivo efficacy in a porcine hoof model.
Results: The optimized formulation showed appropriate viscosity (755.67 cP) and spreadability (7.22 cm), along with smooth texture, good gloss, and a pH suitable for nails (pH 5.2–5.4). Drug permeation studies revealed that the serum enhanced gallic acid penetration more than an aqueous solution. Antifungal studies showed a better zone of inhibition (22.0±0.5 mm) compared to a marketed antifungal product. Cytocompatibility studies indicated more than 88% cell viability. Ex vivo analysis confirmed significant fungal clearance on infected hoof models.
Conclusion: The gallic acid-loaded nail serum developed in this study demonstrated effective antifungal activity, enhanced nail penetration, and favorable physical properties, It offers a natural, safe, and patient-friendly alternative to conventional antifungal treatments for onychomycosis, encouraging further clinical research and potential commercial development.
Keywords: Onychomycosis, Gallic acid, Topical nail serum, Factorial design, L929 fibroblast cells
© 2025 The Authors. Published by Innovare Academic Sciences Pvt Ltd. This is an open access article under the CC BY license (https://creativecommons.org/licenses/by/4.0/)
DOI: https://dx.doi.org/10.22159/ijap.2025v17i6.55068 Journal homepage: https://innovareacademics.in/journals/index.php/ijap
INTRODUCTION
Onychomycosis is a persistent fungal infection predominantly affecting toenails, accounting for approximately 50% of nail disorders. It is primarily caused by dermatophytes such as Trichophyton rubrum and Trichophyton tonsurans, but non-dermatophyte molds (e. g., Aspergillus, Fusarium, Rhizopus) and yeasts like Candida also contribute to its etiology. These fungi invade and degrade keratin in the nails, resulting in symptoms including discoloration, thickening, brittleness, onycholysis (nail separation), and inflammation. The prevalence of this condition is higher among older individuals and is associated with risk factors such as diabetes, tinea pedis, poor circulation, immunosuppression, psoriasis, down syndrome, occlusive footwear, and obesity. The treatment of onychomycosis is challenging due to its high recurrence rate and the difficulty in achieving a complete cure. Therapeutic options include oral antifungals such as terbinafine, itraconazole, and fluconazole, which may have serious side effects and interactions with other medications. Terbinafine is often preferred for dermatophyte infections, although concerns about resistance and hepatotoxicity exist. Topical treatments, including amorolfine and ciclopirox, are also employed, particularly for mild cases. These are applied directly to the nail, minimizing the risk of drug interactions, but they may cause side effects such as burning, itching, and irritation [1, 2].
A serum is a concentrated formulation designed to deliver active ingredients directly to a specific area of the skin, hair, or nails. Serums are typically lighter in texture and possess smaller molecules, allowing for deeper penetration into the skin or hair. A nail serum is a targeted treatment formulated to enhance the health and strength of both nails and cuticles. Composed of concentrated ingredients such as vitamins, proteins, oils, and antioxidants, these serums nourish and repair damaged nails, improving their appearance and helping to prevent issues such as brittleness, cracking, and peeling. Nail serums are commonly used to hydrate and soften the cuticles, promote nail growth, and improve the overall condition of the nails. Typically applied directly to the nails and cuticles in the form of a liquid or gel with a brush, they are gently massaged in for optimal absorption. Consistent use can result in healthier, stronger nails over time [3].
Gallic acid, a potent antioxidant found in various plant species, offers multiple health benefits, including anti-inflammatory, anticancer, antifungal, and antioxidant effects [4]. It has shown promise as a supportive treatment for onychomycosis, a fungal nail infection. Its antifungal properties target fungi like Trichophyton species and candida species, inhibiting their growth and preventing the infection from spreading. Gallic acid’s antioxidant properties help reduce oxidative stress, supporting the nails' strength and preventing further damage, which is common in fungal infections. Additionally, compared to other polyphenols like catechin or quercetin it has superior water solubility, stronger antifungal potency, and a safer profile. Gallic acid’s anti-inflammatory properties can alleviate redness, swelling, and discomfort around the affected nails, promoting a more comfortable healing process [5-8].
The current study involves the use of gallic acid for the preparation of nail serum to treat onychomycosis. The increasing resistance to conventional antifungal agents and the side effects associated with their use have emphasized the need for alternative therapies in managing onychomycosis. Conventional oral treatments, like terbinafine, is commonly used for onychomycosis but pose risks of hepatotoxicity, gastrointestinal distress, and significant drug interactions, making them unsuitable for long-term use in certain populations, such as the elderly or individuals with pre-existing liver conditions [9]. Topical treatments are generally safer but have limited efficacy due to poor nail plate penetration and high recurrence rates remain a challenge, leading to the exploration of new therapeutic strategies that combine efficacy, safety, and patient compliance.
Moreover, the use of a serum allows the integration of additional nail-benefiting components like vitamins, essential oils, and peptides that work synergistically with gallic acid to promote overall nail and cuticle health. This holistic approach addresses both the infection and the damage it causes-such as discoloration, thickening, and brittleness-by nourishing and restoring the nail structure [10]. Unlike antifungal monotherapies, gallic acid-based serums offer multi-functional benefits: they combat fungal proliferation, soothe inflammation, reduce oxidative damage, and encourage the regeneration of healthy tissue.
Given the above-mentioned advantages, the development of a gallic acid-based nail serum represents a promising alternative for managing onychomycosis. It combines antifungal efficacy with antioxidant and anti-inflammatory properties, while also promoting nail health and integrity. Therefore, this study aims to formulate and evaluate a gallic acid-containing nail serum as a novel, safe, and effective option for the topical treatment of onychomycosis.
MATERIALS AND METHODS
Materials
Gallic Acid, ethyl acetate, glycerol, tween 20, and ethanol were purchased from Loba Chemie Pvt Ltd, Mumbai. L929 fibroblast cells were procured from national centre for cell science (NCCS) Pune, India. All the other reagents used were of analytical grade.
Methods
Formulation and optimization of gallic acid nail serum
The nail serum designed to treat onychomycosis was formulated using Design of Experiment (DoE) techniques using SAS JMP 18 software to achieve optimal results [11]. The serum's primary components include gallic acid, acetone, coconut oil, ethyl acetate, glycerol, and tween 20. Gallic acid offers antifungal and antioxidant properties, while coconut oil and glycerol provide moisturizing and calming effects. Ethyl acetate and acetone serve as a solvent, enhancing the solubility of active ingredients, and Tween 20 facilitates emulsification. A 2³ full factorial design with a center point was utilized to explore how three critical formulation variables—acetone, ethyl acetate, and glycerol concentrations—affect the viscosity and spreadability of the topical nail serum. Each variable was tested at two levels (low and high), with a center point added to identify any curvature in the response. The formulation process involved first dissolving gallic acid (25 mg) in acetone, further in a separate beaker, ethyl acetate and coconut oil were mixed together. The second solution (ethyl acetate and coconut oil mixture) was then added to the first solution (gallic acid and acetone mixture), and glycerol was slowly incorporated with continuous stirring at 500 rpm using a magnetic stirrer to ensure uniform mixing. Tween 20 (0.1% v/v) was then added to aid emulsification and improve formulation stability. After thorough stirring, the mixture was made up to a final volume with water to achieve consistent concentration. The serum was left undisturbed for 24 h to allow complete blending and stabilization before further evaluation. This approach resulted in nine formulations, as detailed in table 1. The measured responses, viscosity, and spreadability was used to refine the formulations, and a thorough analysis of both the individual (main) effects and the combined (interaction) effects of the formulation components was conducted.
Each formulation was evaluated for its physical characteristics, viscosity, and spreadability. The viscosity and spreadability data were fed into the design to get the optimized formulation, finally, the optimized formulation was subjected to drug permeation, antifungal studies, ex vivo studies and stability to ensure the serum effectiveness in treating onychomycosis while moisturizing and nourishing the skin and nails.
Table 1: Formulation chart of nail serum
| Formulation code | Acetone concentration (% v/v) | Ethyl acetate concentration (% v/v) | Glycerol concentration (% v/v) |
| F1 | 8.5 | 20 | 57.5 |
| F2 | 7 | 25 | 50 |
| F3 | 10 | 25 | 50 |
| F4 | 7 | 25 | 65 |
| F5 | 10 | 15 | 65 |
| F6 | 7 | 15 | 65 |
| F7 | 7 | 15 | 50 |
| F8 | 10 | 25 | 60 |
| F9 | 10 | 15 | 50 |
Physical characteristics
The formulations were evaluated based on their odor, colour, and appearance. The colour of each formulation was visually seen under the white light and black background. The odor was evaluated by human olfactory.
pH: The pH value of all the formulations was determined using a pH meter. The electrodes were inserted directly into the sample and the pH of all the formulations was calculated.
Gloss: A sample of nail serum was placed on the nail and was visually seen and it was compared with that of the marketed product.
Wash ability: A small amount of serum was applied to the nail and washed under running tap water.
Smoothness to flow: Formulations were poured on the glass slide from a height of 1.5 inches and were spread out. The sample was spread on the glass plate and made the glass slide tilt [12].
Non-volatile content: The sample (1 ml) was placed in a Petri dish and the weight of the empty petridish (W₁) was taken along with the sample before the test (W₂) in the hot air oven for 105 °C. After 1 h the dried sample was taken and cooled, and its weight was taken (W₃). It was calculated by using the following formula [13].

Viscosity
The viscosity of the formulation was determined by Brookfield viscometer using spindle number 96. The serum was placed in a container and the spindle was dipped into it and readings were taken accordingly [14].
Spreadability
In graph paper, 1 ml of serum was placed and coated with glass. Another glass was placed above the serum. The serum diameter was calculated by measuring the diameter of all the sides of the slide. Later, an additional load was added and allowed the serum to stand for about 1 minute, and the diameter of the serum was calculated as before [15].
Drug permeation studies
An in vitro drug permeation study was carried out using a modified Franz diffusion cell using 100 ml of Phosphate-Buffered Saline (PBS) as the medium. A cellophane membrane, sourced from sigma aldrich, was carefully placed between the donor and receptor compartments. The 5 ml of optimized gallic acid serum was placed in the donor compartment. Samples of 1 ml were withdrawn at predetermined time intervals: 0, 10, 20, 30, and 60 min. After each withdrawal, 1 ml of fresh, PBS was added to maintain a constant volume and sink conditions. The withdrawn samples were analysed for drug content using UV-Vis spectrophotometry at 261 nm and the cumulative drug release was calculated and plotted against time to assess the release profile. A similar procedure was followed for 5 ml gallic acid solution (25 mg of gallic acid in 25 ml of distilled water), and the permeation was compared between both [16, 17].
Antifungal activity
The antifungal properties of the optimized gallic acid nail serum was assessed using minimum inhibitory concentration (MIC) method and the agar well diffusion technique.
For MIC determination, double-strength Sabouraud Dextrose Broth (SDB) was prepared, and 2.5 ml was distributed into sterile test tubes for each dilution. A stock solution of the optimized gallic acid serum was prepared at 2000 μg/ml in sterile water. Serial dilutions were made to obtain concentrations of 300, 200, 100, 50, 25, 12.5, and 6.25, μg/ml. Each 2.5 ml dilution was mixed with 2.5 ml of double-strength SDB to achieve final test concentrations. Positive (medium with inoculum, no serum) and negative (medium without inoculum) control tubes were included. Tubes were sterilized at 121 °C for 15 min, cooled, and inoculated with one loopful of Candida albicans standardized to 1–5 × 10³ CFU/ml, except the negative control. Tubes were incubated at 35 °C for 24 h, and the MIC was recorded as the lowest concentration without visible turbidity compared with the positive control.
The antifungal properties of the optimized gallic acid nail serum and a commercially available antifungal lotion (Zole-F, which includes fluocinolone acetonide and miconazole) were assessed using the agar well diffusion technique. Candida albican was selected based on recent clinicoepidemiological evidence indicating that Candida species are prevalent and clinically relevant in onychomycosis cases [18]. A suspension of the fungus candida albicans was prepared and evenly spread on sterile Sabouraud Dextrose Agar (SDA) plates to ensure uniform distribution. Once the agar had set, wells with a consistent diameter (usually 6 mm) were aseptically created in the medium using a sterile cork borer. Each well was then carefully filled with 1 ml of the respective formulation. The inoculated plates were incubated at a temperature of 28–30 °C for 24 h under sterile conditions. Following incubation, the inhibition zones (clear areas around each well indicating the suppression of fungal growth) were measured in millimeters using a calibrated ruler. The size of these inhibition zones was used to compare the antifungal effectiveness of the optimized serum with the commercial product [19].
In vitro cytocompatibility study
The in vitro cytocompatibility study was performed using an MTT assay in accordance with safety testing guidelines established by the Organisation for Economic Co-operation and Development (OECD). The in vitro cytocompatibility study was done using L929 fibroblast cells, which were maintained in Dulbecco's Modified Eagle Medium (DMEM) with the addition of 10% Fetal Bovine Serum (FBS) and 1% penicillin-streptomycin, at a temperature of 37 °C in an incubator with 5% CO₂. The cells were plated into a 96-well plate at a density of 5 × 10⁴ cells per well and left to adhere for 24 h. Various concentrations of optimized nail serum and gallic acid were introduced to the wells, followed by a 72 h incubation period. Wells treated with culture medium alone (0% concentration of test substances) served as the control group. Cell viability was evaluated using the MTT assay, with absorbance readings taken at 570 nm using a microplate reader to calculate viability percentages. Morphological changes were examined under an inverted microscope to evaluate cytotoxic effects. A high viability rate (>80%) indicates good cytocompatibility, whereas reduced viability points to cytotoxicity [20].
Ex vivo evaluation using porcine hoof model
Freshly excised porcine hooves were employed as an ex vivo model to evaluate the efficacy of topical antifungal agents. Due to their structural similarity to human nails, porcine hooves serve as a relevant and reliable biological substrate for studying fungal infections and drug penetration in this preliminary study. However, slight differences in keratin composition and density exist; therefore, for more clinically relevant data, human nail clippings can be used as the substrate for ex vivo and in vitro evaluations.
The hooves were thoroughly cleaned and sterilized to eliminate external contaminants. Subsequently, they were sectioned into uniform flat discs. These discs were used as the substrate for fungal inoculation. The prepared hoof discs were inoculated with Candida albicans to simulate fungal infection. A 100 µl aliquot of fungal suspension was spread over the surface of nutrient agar using a sterile spatula, and the hoof discs were placed in contact with the inoculated agar. The infection was allowed to develop over 5 days at 32 °C. Following the incubation period, the hoof discs were subjected to histopathological analysis to confirm fungal elements. Infected discs were then placed on fresh agar plates and treated with the optimized nail serum and a marketed antifungal formulation (zole-F). Three drops of the serum were applied topically to each disc once daily for 7 consecutive days. After the treatment period, the discs were stained with Periodic Acid-Schiff (PAS) stain and analyzed histologically under a light microscope using a 40× objective magnification to assess the extent of fungal eradication. This ex vivo model provides a more physiologically relevant system compared to traditional in vitro assays, enabling a comprehensive evaluation of both antifungal activity and drug penetration through nail tissue [21, 22].
RESULTS AND DISCUSSION
Formulation and optimization of gallic acid nail serum
All nine formulations were systematically developed and evaluated for viscosity and spreadability, and the resulting data (table 2) were analyzed using a factorial design approach. This statistical method enabled the assessment of not only the individual effects of each ingredient but also their interactive influences on the response variables. The Analysis of Variance (ANOVA) results are depicted in table 3 where both the p-values and their corresponding logworth values (–log₁₀ of the p-value) are presented. A higher Logworth indicates greater statistical significance, helping to rank the relative impact of each factor on the response [11]. The ANOVA results demonstrated that both viscosity and spreadability were significantly influenced by the interaction of formulation variables. The interaction between ethyl acetate and glycerol concentration was highly significant (p = 0.00098), suggesting a strong combined effect on both responses. Likewise, the interactions between acetone concentration and glycerol concentration (p = 0.00343), and between acetone and ethyl acetate (p = 0.00449), were also statistically significant, indicating that the interplay between solvents plays a crucial role in modulating formulation characteristics. Among the individual factors, glycerol concentration (p = 0.00881) and acetone concentration (p = 0.02378) showed significant effects on viscosity and spreadability, while ethyl acetate concentration (p = 0.05132) had a marginal influence. The addition of coconut oil likely buffered the impact of ethyl acetate on the serum’s rheological characteristics by increasing overall formulation viscosity and promoting a stable oil phase, thereby diminishing ethyl acetate’s standalone influence. These findings highlight the need for careful optimization of both individual components and their interactions to achieve a formulation with desired viscosity and spreadability.
The actual versus predicted plots for viscosity and spreadability demonstrate a strong correlation between experimental and model-predicted values. For viscosity, the model exhibited an excellent fit with an R² value of 0.99874, a low RMSE of 33.251, and a significant p-value of 0.0038, indicating high predictive accuracy and reliability as shown in fig. 1. Similarly, the spreadability model showed a strong fit (fig. 2) with an R² value of 0.98733, an RMSE of 0.6346, and a p-value of 0.0375, confirming that the model adequately captured the variability in the data. The narrow confidence intervals and close clustering of data points around the regression line further validate the robustness of the predictive models for both responses.
Table 2: Viscosity and spreadability results
| Formulation | Viscosity (centipoise) | Spreadability (cm) |
| F1 | 800±0.816 | 8±0.349 |
| F2 | 900±9.797 | 3±0.763 |
| F3 | 1500±0.816 | 5±0.608 |
| F4 | 500±1.632 | 12±0.577 |
| F5 | 600±2.449 | 8±0.763 |
| F6 | 1500±1.632 | 9±1.00 |
| F7 | 400±3.265 | 4±1.00 |
| F8 | 300±4.082 | 9±2.081 |
| F9 | 301±0.816 | 7±1.00 |
Data of viscosity and spreadability were presented as mean±SD with n = 3
Table 3: ANOVA summary of the impact of ingredients concentrations on viscosity and spreadability
| Source | Log worth | P-Value | Significant (P<0.05) |
| Ethyl acetate * glycerol concentration | 3.008 | 0.00098 | Yes |
| Acetone concentration * glycerol concentration | 2.464 | 0.00343 | Yes |
| Acetone concentration * ethyl acetate | 2.348 | 0.00449 | Yes |
| Glycerol concentration (50,65) | 2.055 | 0.00881 | Yes |
| Acetone concentration (7,10) | 1.624 | 0.02378 | Yes |
| Ethyl acetate (15,25) | 1.290 | 0.05132 | No |

Fig. 1: Actual versus predicted plots for viscosity

Fig. 2: Actual versus predicted plots for spreadability

Fig. 3: Prediction profiler
The prediction profiler demonstrated the combined influence of acetone, ethyl acetate, and glycerol concentrations on both the viscosity and spreadability of the formulation (fig. 3). A slight reduction in acetone concentration resulted in a decrease in viscosity, aiding better formulation flow, while maintaining adequate spreadability. Ethyl acetate concentration had a minor effect on viscosity but contributed moderately to improving spreadability. An increase in glycerol concentration led to an enhancement in spreadability, while also stabilizing viscosity within an acceptable range. Overall, the desirability plot indicated that the formulation achieved optimal properties when the independent variables were maintained within specific limits.
Based on the optimization, the suggested optimum concentrations were acetone at 8.5%, ethyl acetate at 20%, and glycerol at 57.5%. At these levels, the formulation exhibited a viscosity of approximately 755.67 cP, ensuring good consistency and application feel, and a spreadability of 7.22 cm, supporting ease of application. The overall desirability value of 0.845 confirmed that the optimized formulation achieved a satisfactory balance between viscosity and spreadability.
Physical characteristics
All the nine formulations (F1 to F9) were evaluated for physical characteristics. Upon examining all nine formulations (F1–F9), it was found that they consistently exhibited favorable characteristics across all evaluated parameters. Each formulation appeared as a clear, colorless liquid with a smooth, non-sticky texture, indicating a uniform physical appearance and feel. The pH levels ranged from 5.16 to 5.44, which is within the acceptable range for topical use, ensuring compatibility with the skin. The nonvolatile content remained stable across the formulations, with a narrow range from 82.59% to 82.73%, indicating minimal evaporation and good formulation stability. All samples were easy to wash off, demonstrated good flow smoothness, and had a pleasing gloss, reflecting favorable rheological and aesthetic properties suitable for topical application. Overall, the formulations consistently met the desired physical parameters for further development or evaluation.
Viscosity and spreadability
The spreadability and viscosity of the formulations are depicted in table 2. The spreadability of serum is its ability to spread on the surface of the nail. Good spreadability ranges from 5-7 cm and the serum’s spreadability was within this range [15]. The greater the scatter diameter, the greater is the surface area reached by the nail serum. The viscosity of the nail serum was determined by using a brookfield viscometer and was within the acceptable range.
Drug permeation studies
An in vitro drug permeation study was performed in the Franz diffusion cell for 60 min using phosphate-buffered saline (PBS) as the medium for release. The quantification of gallic acid released at specific intervals was achieved through UV-visible spectrophotometry at 261 nm. The study compared the drug permeation profiles of an optimized gallic acid nail serum and a gallic acid aqueous solution. Samples of 1 ml were taken at set times (0, 12, 24, 36, 48, and 60 min) and replaced with fresh PBS to maintain sink conditions. The fig. 4 illustrates that drug permeation from the formulation increased progressively over time. The optimized nail serum showed a notably higher permeation, achieving about 90% drug permeation at 60 min, while the aqueous solution reached approximately 65% at the same time. The improved permeation observed with the serum is likely attributable to the combined effect of glycerol and coconut oil, which function as permeation enhancers by hydrating and softening the dense keratin structure of the nail plate, thereby facilitating greater drug diffusion. Glycerol, as a humectant, maintains moisture within the nail matrix, increasing its porosity, while coconut oil may help to disrupt the lipid-protein interfaces in keratin layers [23]. Additionally, Tween 20, acting as an emulsifier, stabilizes the formulation and improves the uniform distribution of gallic acid, promoting consistent drug release and better contact with the nail surface.
Antifungal activity evaluation
In the MIC assay, the positive control (broth with Candida albicans but no serum) showed turbidity, confirming fungal growth, while the negative control (broth without inoculum) remained clear, verifying sterility. The optimized gallic acid serum showed no turbidity at concentrations ≥200 μg/ml, similar to the negative control, indicating effective inhibition of fungal growth. In contrast, lower concentrations exhibited turbidity like the positive control, suggesting insufficient antifungal activity.
The antifungal efficacy of a gallic acid-based nail serum was further evaluated comparing the zone of inhibition with commercially available antifungal topical formulation, as depicted in fig. 5 and fig. 6. It is seen that both formulations exhibited zones of inhibition, demonstrating their antifungal effectiveness. The optimized gallic acid serum showed a zone of inhibition of 22.0±0.5 mm, while the commercial antifungal product showed 20.0±0.3 mm, indicating the gallic acid serum had a relative inhibition of 110% compared to the standard. This result underscores the antifungal properties of gallic acid as an active ingredient. The ability of the formulated serum to produce results comparable to the commercial product highlights its promise as a cost-effective, plant-based alternative, further, minimum inhibitory concentration and in vivo evaluations in the future will strengthen these findings and explore the serum’s potential for broader clinical application [24].

Fig. 4: Drug permeation study of optimised nail serum of gallic acid and gallic acid solution (n=3)
Fig. 5: Zone of inhibition of marketed product
Fig. 6: Zone of inhibition of optimized gallic acid nail serum
In vitro cytocompatibility study
An MTT assay was conducted to evaluate the cytocompatibility of the optimized gallic acid nail serum over a concentration range from 0.25% to 5% in L929 fibroblast cells. An untreated control (0% concentration) was included for effective comparison, which showed 100% cell viability. The study also compared the serum with a gallic acid aqueous solution to identify any differences in cell toxicity between the pure drug and the formulation. The fig. 7, illustrates the cell viability percentage at each concentration for both the optimized serum and the solution. At all concentrations tested, both formulations maintained cell viability above 85%, demonstrating their non-toxic nature to the cells examined. Even at the maximum concentration of 5%, cell viability exceeded 88% for both formulations, with the serum showing slightly better tolerance than the solution. This indicates that the optimized gallic acid nail serum is safe and biocompatible, making it appropriate for topical use in treating onychomycosis without damaging the surrounding healthy tissue [25].

Fig. 7: In vitro cytocompatibility study in L929 fibroblast cells (n=3)
Ex-vivo study evaluation
The histological section of hoof tissue infected with candida albicans are shown in fig. 8. The tissue displays abundant fungal structures, including pseudohyphae, blastospores (yeast cells), and hyphal elements, indicating active fungal invasion and tissue disruption [26]. In contrast, Fig. 9 (hoof tissue treated with the optimized nail serum) reveals a marked reduction in fungal structures, with no visible pseudohyphae, blastospores, or hyphae. The hoof tissue architecture appears preserved, indicating that treatment with the serum significantly decreased fungal growth. Similarly, fig. 10 (hoof tissue treated with the marketed formulation) also shows the absence of fungal elements, maintaining the integrity of the tissue. The substantial reduction in fungal colonization observed in fig. 9 demonstrates that the developed nail serum effectively inhibits candida albicans growth. The histopathological results indicate that the serum formulation exhibits antifungal efficacy comparable to the marketed product, thereby supporting its potential use in treating fungal infections of the nail or hoof tissue.

Fig. 8: Histological section of porcine hoof nail tissue infected with Candida albicans

Fig. 9: Histopathology section of porcine hoof nail tissue treated with the optimized nail serum

Fig. 10: Histopathology section of hoof nail tissue treated with the marketed formulation
CONCLUSION
In the present study, a gallic acid-loaded nail serum was formulated, optimized, and evaluated with the objective of treating onychomycosis as an alternative to conventional dosage forms. Conventional treatments are associated with adverse reactions, including systemic side effects, drug resistance, and high recurrence rates. A systematic 2³ factorial design approach was employed to optimize the formulation for key parameters such as viscosity and spreadability, and the optimum formulation was identified. The prepared nail serum exhibited desirable physical properties, including a smooth and non-sticky texture, appropriate pH, good gloss, and excellent washability.
The permeation studies demonstrated enhanced drug delivery across the nail barrier compared to a plain gallic acid solution. Cytocompatibility studies conducted on L929 fibroblast cells indicated more than 88% cell viability. Antifungal testing revealed that the developed serum had required minimum inhibitor concentration and provided a zone of inhibition slightly superior to that of a marketed antifungal product, and ex vivo studies on porcine hoof models further confirmed the serum's effectiveness in significantly reducing fungal infection. The study underscores the potential of plant-derived compounds in managing onychomycosis using a novel topical nail serum and encourages further antifungal studies in animal models, long-term stability, and finally clinical trials to confirm its safety and effectiveness in patients.
ACKNOWLEDGEMENT
Author would like to thank Nitte DU and NGSM institute of Pharmaceutical Sciences for providing the necessary facility to perform this study.
FUNDING
Nil
AUTHORS CONTRIBUTIONS
Ashwini M conceived and designed the study, supervised the work, and was responsible for writing, reviewing, and editing the manuscript. Diya Polali and Jane Glenisha Lobo performed the laboratory experiments and collected data. Joel Sylvester Saldanha conducted experiments, analyzed data, and assisted in writing the manuscript. Jenitta Maria Carmel assisted with laboratory work and supported experimental procedures. All authors have read and approved the final version of the manuscript.
CONFLICT OF INTERESTS
Authors do not have conflict of interest
REFERENCES
Litaiem N, Mnif E, Zeglaoui F. Dermoscopy of onychomycosis: a systematic review. Dermatol Pract Concept. 2023 Jan 1;13(1):e2023072. doi: 10.5826/dpc.1301a72, PMID 36892372.
Mohsin SA, Shaukat S, Nawaz M, Ur Rehman T, Irshad N, Majid M. Appraisal of selected ethnomedicinal plants as alternative therapies against onychomycosis: evaluation of synergy and time kill kinetics. Front Pharmacol. 2022 Nov 24;13:1067697. doi: 10.3389/fphar.2022.1067697, PMID 36506532.
Khan N, Ahmed S, Sheraz MA, Anwar Z, Ahmad I. Pharmaceutical based cosmetic serums. Profiles Drug Subst Excip Relat Methodol. 2023 Jan 1;48:167-210. doi: 10.1016/bs.podrm.2022.11.006, PMID 37061274.
Khan MS, Fatima M, Wahab S, Khalid M, Kesharwani P. Gallic acid loaded self-nanoemulsifying hydrogel-based drug delivery system against onychomycosis. Nanomedicine (Lond). 2024 Oct 20;19(25):2065-83. doi: 10.1080/17435889.2024.2386923, PMID 39143900.
Davidova S, Galabov AS, Satchanska G. Antibacterial antifungal antiviral activity and mechanisms of action of plant polyphenols. Microorganisms. 2024 Dec 4;12(12):2502. doi: 10.3390/microorganisms12122502, PMID 39770706.
Riaz Z, Baddi S, Gao F, Feng CL. Gallic acid-doped multifunctional hybrid hydrogel for antioxidant and antibacterial studies. Eur Polym J. 2024 Feb 21;206:112778. doi: 10.1016/j.eurpolymj.2024.112778.
Fan G, Xu Z, Liu X, Yin W, Sun L, Wu D. Antifungal efficacy of gallic acid extracted from pomegranate peel against Trichophyton rubrum: in vitro case study. Nat Prod Commun. 2023;18(1):1-6. doi: 10.1177/1934578X221148607.
Borgohain P, Saikia LR, Mahanta J. Herbal medicine as an alternative for the treatment of onychomycosis. Int J Bot Stud. 2022;7(2):29-34.
Brown A, Potesta M, Hameed A. Drug-induced liver injury secondary to terbinafine use. Cureus. 2024 Feb 19;16(2):e54453. doi: 10.7759/cureus.54453, PMID 38510874, PMCID PMC10952058.
Mohsin SA, Shaukat S, Nawaz M, Ur Rehman T, Irshad N, Majid M. Appraisal of selected ethnomedicinal plants as alternative therapies against onychomycosis: evaluation of synergy and time kill kinetics. Front Pharmacol. 2022 Nov 24;13:1067697. doi: 10.3389/fphar.2022.1067697, PMID 36506532.
Puri V, Froelich A, Shah P, Pringle S, Chen K, Michniak Kohn B. Quality by design guided development of polymeric nanospheres of terbinafine hydrochloride for topical treatment of onychomycosis using a nano-gel formulation. Pharmaceutics. 2022 Oct 12;14(10):2170. doi: 10.3390/pharmaceutics14102170, PMID 36297605.
Dehari D, Mehata AK, Priya V, Parbat D, Kumar D, Srivastava AK. Luliconazole nail lacquer for the treatment of onychomycosis: formulation characterization and in vitro and ex vivo evaluation. AAPS PharmSciTech. 2022 Jun 24;23(6):175. doi: 10.1208/s12249-022-02324-7, PMID 35750993.
Aldawsari MF, Alkholifi FK, Foudah AI, Alqarni MH, Alam A, Salkini MA. Gallic acid-loaded PLGA nanoparticles: a promising transdermal drug delivery system with antioxidant and antimicrobial agents. Pharmaceuticals (Basel). 2023 Aug 24;16(8):1090. doi: 10.3390/ph16081090, PMID 37631005.
Anjum A, Shabbir K, Din FU, Shafique S, Zaidi SS, Almari AH. Co-delivery of amphotericin B and pentamidine loaded niosomal gel for the treatment of cutaneous leishmaniasis. Drug Deliv. 2023 Dec 31;30(1):2173335. doi: 10.1080/10717544.2023.2173335, PMID 36722301.
Gugleva V, Ivanova N, Sotirova Y, Andonova V. Dermal drug delivery of phytochemicals with phenolic structure via lipid based nanotechnologies. Pharmaceuticals (Basel). 2021 Aug 24;14(9):837. doi: 10.3390/ph14090837, PMID 34577536.
Elshall AA, Ghoneim AM, Abdel Mageed HM, Osman R, Shaker DS. Ex vivo permeation parameters and skin deposition of melatonin-loaded microemulsion for treatment of alopecia. Futur J Pharm Sci. 2022 May 18;8(1):28. doi: 10.1186/s43094-022-00418-4.
Kasar PK, Kamble MA, Biyani KR, Kumbhar ST, Vidhate BV. Formulation and evaluation of topical gel of itraconazole. Int J Curr Pharm Res. 2018;10(1):32-5.
Manjubaashini N, Bargavi P, Balakumar S. Bioceramic and polycationic biopolymer nanocomposite scaffolds for improved wound self-healing and anti-inflammatory properties: an in vitro study. Biomater Sci. 2023;11(11):3921-37. doi: 10.1039/d3bm00169e, PMID 37092809.
Perissato BL, Dos Santos Pedroso R. Medicinal plants and onychomycosis: potential and evidence of antifungal activity an integrative review of the literature. J Med Plants Res. 2022 Jul 31;16(7):230-44. doi: 10.5897/JMPR2022.7239.
Javaid A, Sharma KK, Ka A, Verma A, Mudavath SL. Therapeutic potential of molsidomine loaded liquid crystal nanoparticles for the treatment and management of niacin-induced varicose veins: in vitro and in vivo studies. ACS Appl Bio Mater. 2024 Sep 24;7(11):7306-23. doi: 10.1021/acsabm.4c00980, PMID 39316777.
Ghannoum MA, Long L, Isham N, Bulgheroni A, Setaro M, Caserini M. Ability of hydroxypropyl chitosan nail lacquer to protect against dermatophyte nail infection. Antimicrob Agents Chemother. 2015 Apr;59(4):1844-8. doi: 10.1128/AAC.04842-14, PMID 25547349.
Temporiti ME, Guerini M, Baiguera RM, Buratti S, Desiderio A, Goppa L. Efficacy of bovine nail membranes as in vitro model for onychomycosis infected by trichophyton species. J Fungi (Basel). 2022 Oct 27;8(11):1133. doi: 10.3390/jof8111133, PMID 36354900.
Fluhr JW, Darlenski R, Surber CJ. Glycerol and the skin: holistic approach to its origin and functions. Br J Dermatol. 2008 Jul 1;159(1):23-34. doi: 10.1111/j.1365-2133.2008.08643.x, PMID 18510666.
Singh V, Verma R, Mittal V, Kaushik D. Preparation, evaluation and in vivo studies of novel herbal lipogel of Ocimum tenuiflorum (L.) extract for acne treatment. Int J App Pharm. 2025;17(4):127-44. doi: 10.22159/ijap.2025v17i4.53761.
Wunnoo S, Sermwittayawong D, Praparatana R, Voravuthikunchai SP, Jakkawanpitak C. Quercus infectoria gall ethanolic extract accelerates wound healing through attenuating inflammation and oxidative injuries in skin fibroblasts. Antioxidants (Basel). 2024 Sep 9;13(9):1094. doi: 10.3390/antiox13091094, PMID 39334753, PMCID PMC11428264.
Gil J, Solis M, Higa A, Davis SC. Candida albicans infections: a novel porcine wound model to evaluate treatment efficacy. BMC Microbiol. 2022;22(1):45. doi: 10.1186/s12866-022-02460-x, PMID 35120444.